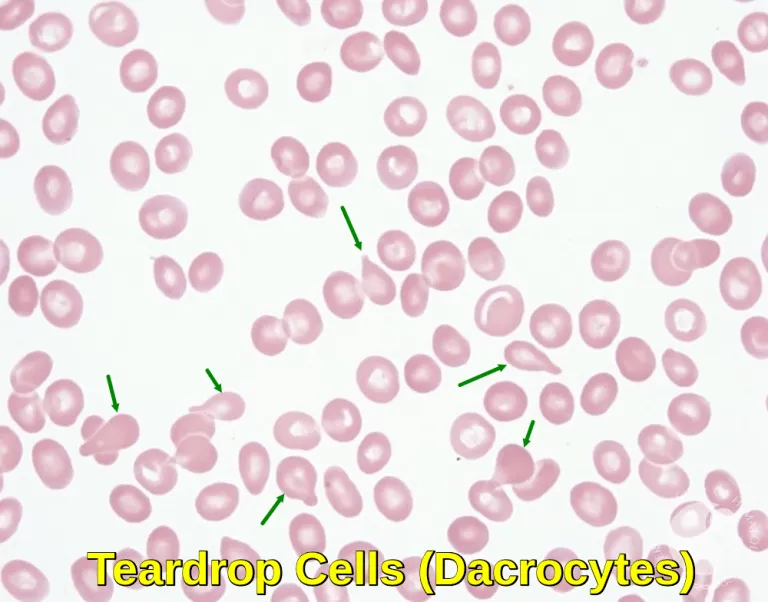
Peripheral smear showing dacrocytes (teardrop cells)

MPNs - Proliferation Party!
- Clonal proliferation of mature myeloid cells, leading to ↑ peripheral blood counts.
- Driven by activating mutations in tyrosine kinases.
- CML: Defined by BCR-ABL1 fusion gene from the Philadelphia chromosome t(9;22).
- PV, ET, PMF: Mostly associated with JAK2 V617F mutation; also CALR or MPL.

⭐ All MPNs risk transformation to acute myeloid leukemia (AML) or a spent phase of myelofibrosis.
CML - The Philly Special
- Pathogenesis: Defined by the Philadelphia (Ph) chromosome, a t(9;22) translocation.
- Creates the BCR-ABL1 fusion gene, a constitutively active tyrosine kinase.
- Drives massive proliferation of mature granulocytes (neutrophils, basophils, eosinophils).
- Presentation:
- Often asymptomatic with incidental leukocytosis.
- Symptomatic: massive splenomegaly, fatigue, weight loss.
- Labs:
- WBC > 100,000/μL.
- ↑ Basophils (pathognomonic).
- ↓ Leukocyte Alkaline Phosphatase (LAP) score.
- Treatment: Tyrosine Kinase Inhibitors (e.g., Imatinib).
translocation)
⭐ CML is distinguished from a benign leukemoid reaction by the presence of the Ph chromosome, ↑ basophils, and a very low LAP score. It can progress to a blast crisis (> 20% blasts), resembling acute leukemia.
Polycythemia Vera - Seeing Red
- Pathophysiology: Neoplastic proliferation of mature myeloid cells, especially RBCs. Driven by JAK2 V617F mutation (>95%), leading to growth factor-independent proliferation.
- Clinical Features:
- Symptoms: Intense pruritus (especially post-shower), headache, erythromelalgia (burning pain).
- Signs: Plethora (ruddy face), splenomegaly, thrombosis/bleeding.
- Lab Findings: ↑ RBC mass/Hct, ↑ Platelets, ↑ WBCs. The key differentiating feature is ↓ serum EPO.
- Treatment: Phlebotomy (target Hct <45%), low-dose aspirin; add hydroxyurea for high-risk patients.
⭐ The combination of generalized pruritus after a hot shower and a decreased serum EPO level is highly specific for Polycythemia Vera.
📌 Mnemonic: Plethora, Visual/Vascular, JAK2 (P.V. JAK).

ET & PMF - Platelets & Pipes
-
Essential Thrombocythemia (ET): ↑ Platelets
- Sustained thrombocytosis (> 450,000/μL) from megakaryocyte proliferation.
- Mutations: JAK2 (~50%), CALR, MPL.
- Clinical: Can cause thrombosis (e.g., stroke) or, paradoxically, bleeding.
- Presents with erythromelalgia (burning pain/redness in hands/feet).
-
Primary Myelofibrosis (PMF): Clogged Pipes
- Megakaryocytes release fibrogenic factors (PDGF, TGF-β) → marrow fibrosis.
- Leads to severe "B" symptoms & massive splenomegaly (extramedullary hematopoiesis).
- Smear: Leukoerythroblastosis & dacrocytes (teardrop cells).
- 📌 Mnemonic: Fibrosis "Tears" up the RBCs.
⭐ Exam Favorite: Primary Myelofibrosis classically results in a "dry tap" on bone marrow aspiration due to extensive reticulin fibrosis.
High‑Yield Points - ⚡ Biggest Takeaways
- All MPNs feature overproduction of mature myeloid cells from activating mutations like JAK2 V617F.
- CML is unique with its BCR-ABL fusion (t(9;22)) and is treated with tyrosine kinase inhibitors.
- Polycythemia Vera (PV) presents with ↑ RBC mass, aquagenic pruritus, and low erythropoietin (EPO).
- Essential Thrombocythemia (ET) is marked by thrombocytosis, leading to thrombosis or hemorrhage.
- Primary Myelofibrosis (PMF) causes marrow fibrosis, splenomegaly, and teardrop cells.
- All risk transformation to myelofibrosis or acute myeloid leukemia (AML).
Unlock the full lesson and continue reading
Signup to continue reading this lesson and unlimited access questions, flashcards, AI notes, and more